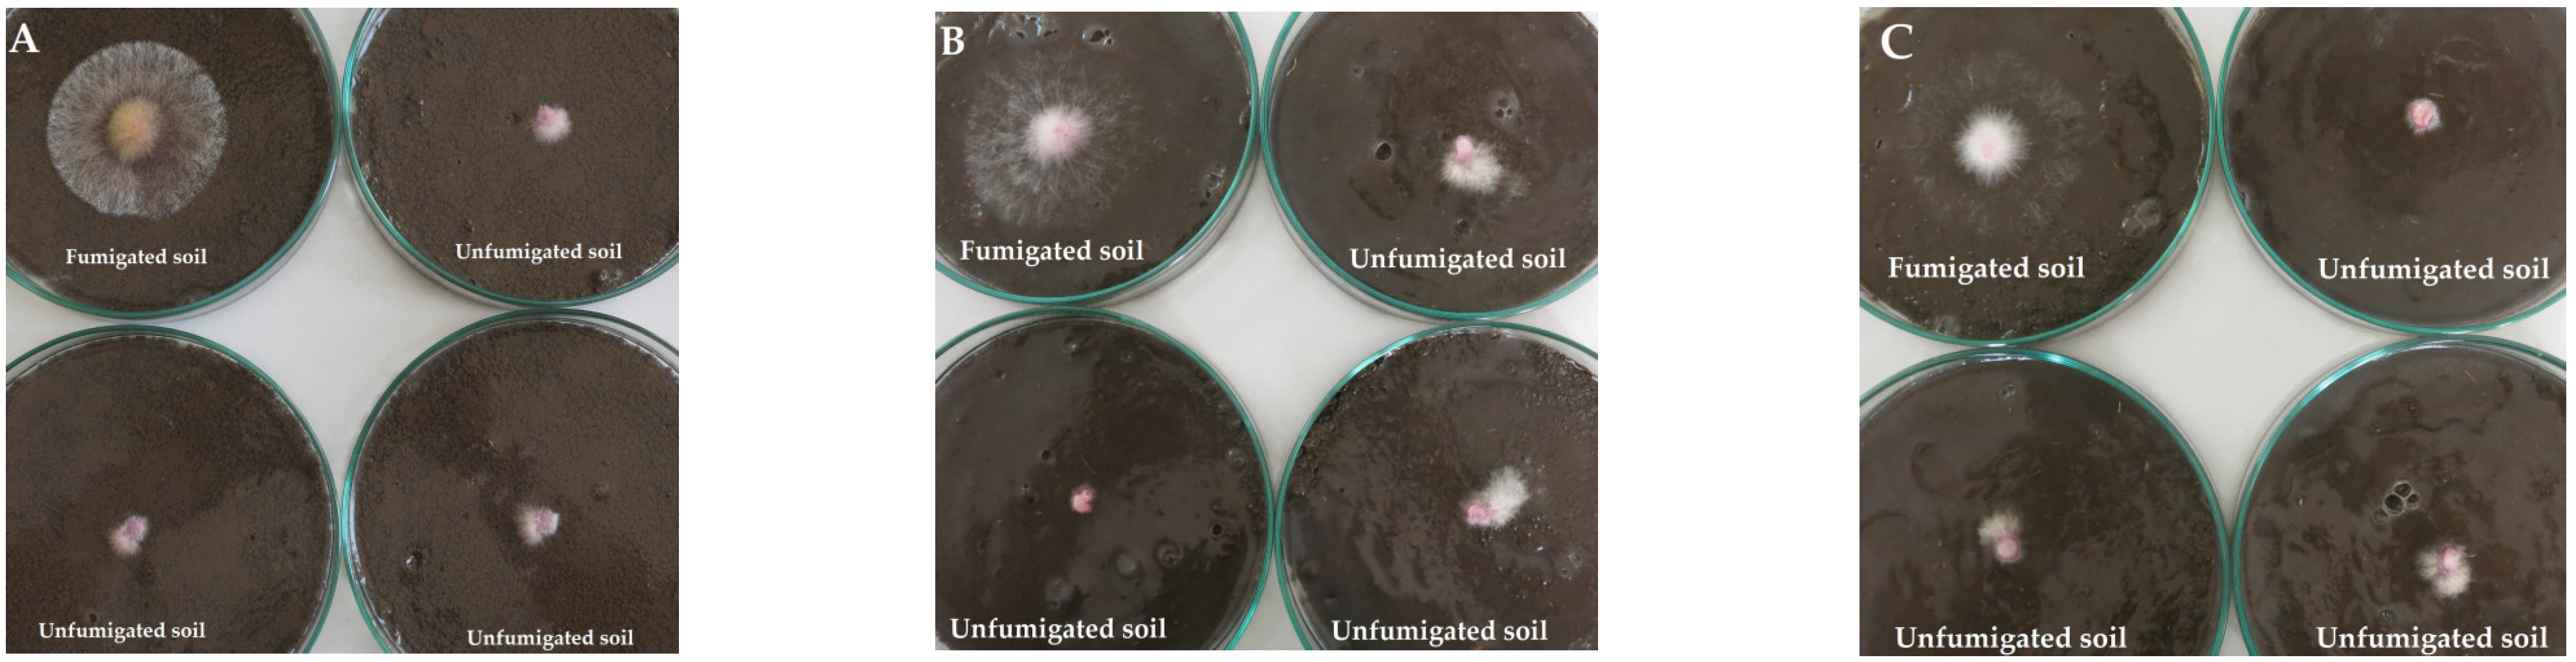

Soil Fungistasis against Fusarium Graminearum under Different tillage Systems
Abstract
1. Introduction
2. Results
2.1. Quantification of F. Graminearum in Soil
2.2. Soil Fungistasis against F. Graminearum
2.3. Antagonistic Activity of Soil Bacteria against F. Graminearum
3. Discussion
4. Materials and Methods
4.1. Study Site and Experiment Description
4.2. Collection of Soil Samples
4.3. Quantification of F. Graminearum in Soil
4.4. Soil Fungistasis
4.5. Soil Fumigation
4.6. Isolation of Soil Bacteria and Evaluation of Antagonistic Activity against F. Graminearum
4.7. Identification of Antagonistic Bacteria
4.8. Meteorological Conditions
4.9. Statistical Analyses
5. Conclusions
Supplementary Materials
Author Contributions
Funding
Institutional Review Board Statement
Informed Consent Statement
Data Availability Statement
Acknowledgments
Conflicts of Interest
References
- Zhang, S.; Li, Q.; Lu, Y.; Sun, X.; Jia, S.; Zhang, X.; Liang, W. Conservation tillage positively influences the microflora and microfauna in the black soil of Northeast China. Soil Till. Res. 2015, 149, 46–52. [Google Scholar] [CrossRef]
- Feiziene, D.; Feiza, V.; Karklins, A.; Versuliene, A.; Janusauskaite, D.; Antanaitis, S. After-effects of long-term tillage and residue management on topsoil state in Boreal conditions. Eur. J. Agron. 2018, 94, 12–24. [Google Scholar] [CrossRef]
- Steponavičienė, V.; Bogužas, V.; Sinkevičienė, A.; Skinulienė, L.; Sinkevičius, A.; Klimas, E. Soil physical state as influenced by longterm reduced tillage, no-tillage and straw management. Zemdirbyste 2020, 107, 195–202. [Google Scholar] [CrossRef]
- Liaudanskiene, I.; Zukaitis, T.; Velykis, A.; Satkus, A.; Parasotas, I. The impact of tillage practices on the distribution of humified organic carbon in a clay loam. Zemdirbyste 2021, 108, 11–18. [Google Scholar] [CrossRef]
- Velykis, A.; Satkus, A. The impact of tillage, Ca-amendent and cover crop on the physical state of clay loam soil. Zemdirbyste 2018, 105, 3–10. [Google Scholar] [CrossRef]
- Veršulienė, A.; Kadžienė, G.; Kochiieru, M.; Pranaitienė, S.; Meškauskienė, L.; Auškalnienė, O. Response of spring barley root and soil physical properties to changes under cover crop and different tillage. Zemdirbyste 2022, 109, 291–296. [Google Scholar] [CrossRef]
- Scherner, A.; Melander, B.; Jensen, P.K.; Kudsk, P.; Avila, L.A. Reducing tillage intensity affects the cumulative emergence dynamics of annual grass weeds in winter cereals. Weed Res. 2017, 57, 314–322. [Google Scholar] [CrossRef]
- Auškalnienė, O.; Kadžienė, G.; Janušauskaitė, D.; Supronienė, S. Changes in weed seed bank and flora as affect by soil tillage systems. Zemdirbyste 2018, 105, 221–226. [Google Scholar] [CrossRef]
- Kadziene, G.; Suproniene, S.; Auskalniene, O.; Pranaitiene, S.; Svegzda, P.; Versuliene, A.; Ceseviciene, J.; Janusauskaite, D.; Feiza, V. Tillage and cover crop influence on weed pressure and Fusarium infection in spring cereals. Crop Prot. 2020, 127, 104966. [Google Scholar] [CrossRef]
- Sharma-Poudyal, D.; Schlatter, D.; Yin, C.; Hulbert, S.; Paulitz, T. Long-term no-till: A major driver of fungal communities in dryland wheat cropping systems. PloS ONE 2017, 12, e0184611. [Google Scholar] [CrossRef]
- Pereyra, S.A.; Dill-Macky, R. Colonisation of residues of diverse plant species by Gibberella zeae and their contribution to Fusarium head blight inoculum. Plant Dis. 2008, 92, 800–807. [Google Scholar] [CrossRef] [PubMed]
- Suproniene, S.; Mankeviciene, A.; Kadziene, G.; Feiziene, D.; Feiza, V.; Semaskiene, R.; Dabkevicius, Z. The effect of different tillage-fertilization practices on the mycoflora of wheat grains. Agric. Food Sci. 2011, 20, 315–326. [Google Scholar] [CrossRef]
- Hofgaard, I.S.; Seehusen, T.; Aamot, H.U.; Riley, H.; Razzaghian, J.; Le, V.H.; Hjelkrem, A.G.R.; Dill-Macky, R.; Brodal, G. Inoculum potential of Fusarium spp. relates to tillage and straw management in Norwegian fields of spring oats. Front. Microbiol. 2016, 7, 556. [Google Scholar] [CrossRef] [PubMed]
- Supronienė, S.; Sakalauskas, S.; Mankevičienė, A.; Barčauskaitė, K.; Jonavičienė, A. Distribution of B type trichothecene producing Fusarium species in wheat grain and relation to mycotoxins DON and NIV concentrations. Zemdirbyste 2016, 103, 281–288. [Google Scholar] [CrossRef]
- Gunupuru, L.R.; Perochon, A.; Doohan, F.M. Deoxynivalenol resistance as a component of FHB resistance. Trop. Plant Pathol. 2017, 42, 175–183. [Google Scholar] [CrossRef]
- Janaviciene, S.; Suproniene, S.; Kadziene, G.; Pavlenko, R.; Berzina, Z.; Bartkevics, V. Toxigenicity of F. graminearum residing on host plants alternative to wheat as influenced by environmental conditions. Toxins 2022, 14, 541. [Google Scholar] [CrossRef]
- Yli-Mattila, T. Ecology and evolution of toxigenic Fusarium species in cereals in Northern Europe and Asia. J. Plant Pathol. 2010, 92, 7–18. Available online: http://www.jstor.org/stable/41998764 (accessed on 30 December 2022).
- Nielsen, L.K.; Jensen, J.D.; Rodríguez, A.; Jørgensen, L.N.; Justesen, A.F. TRI12 based quantitative real-time PCR assays reveal the distribution of trichothecene genotypes of F. graminearum and F. culmorum isolates in Danish small grain cereals. Int. J. Food Microbiol. 2012, 157, 384–392. [Google Scholar] [CrossRef]
- Kelly, A.C.; Clear, R.M.; O’Donnell, K.; McCormick, S.; Turkington, T.K.; Tekauz, A.; Gilbert, J.; Kistler, H.C.; Busman, M.; Ward, T.J. Diversity of Fusarium head blight populations and trichothecene toxin types reveals regional differences in pathogen composition and temporal dynamics. Fungal Genet. Biol. 2015, 82, 22–31. [Google Scholar] [CrossRef]
- Parikka, P.; Hakala, K.; Tiilikkala, K. Expected shifts in Fusarium species’ composition on cereal grain in Northern Europe due to climatic change. Food Addit. Contam. Part A 2012, 29, 1543–1555. [Google Scholar] [CrossRef]
- Bernhoft, A.; Torp, M.; Clasen, P.E.; Løes, A.K.; Kristoffersen, A.B. Influence of agronomic and climatic factors on Fusarium infestation and mycotoxin contamination of cereals in Norway. Food Addit. Contam. 2012, 29, 1129–1140. [Google Scholar] [CrossRef] [PubMed]
- West, J.S.; Holdgate, S.; Townsend, J.A.; Edwards, S.G.; Jennings, P.; Fitt, B.D.L. Impacts of changing climate and agronomic factors on fusarium ear blight of wheat in the UK. Fungal Ecol. 2012, 5, 53–61. [Google Scholar] [CrossRef]
- Yuan, X.; Hong, S.; Xiong, W.; Raza, W.; Shen, Z.; Wang, B.; Li, R.; Ruan, Y.; Shen, Q.; Dini-Andreote, F. Development of fungal-mediated soil suppressiveness against Fusarium wilt disease via plant residue manipulation. Microbiome 2021, 9, 200. [Google Scholar] [CrossRef] [PubMed]
- Lockwood, J.L. Fungistasis in soils. Biol. Rev. Camb. Philos. Soc. 1977, 52, 1–43. [Google Scholar] [CrossRef]
- Bonanomi, G.; Gaglione, S.A.; Incerti, G.; Zoina, A. Biochemical quality of organic amendments affects soil fungistasis. Appl. Soil Ecol. 2013, 72, 135–142. [Google Scholar] [CrossRef]
- Wu, M.; Zhang, H.; Li, X.; Zhang, Y.; Su, Z.; Zhang, C. Soil fungistasis and its relations to soil microbial composition and diversity: A case study of a series of soils with different fungistasis. J. Environ. Sci. 2008, 20, 871–877. [Google Scholar] [CrossRef]
- Donn, S.; Almario, J.; Muller, D.; Moënne-Loccoz, Y.; Gupta, V.V.; Kirkegaard, J.A.; Richardson, A.E. Rhizosphere microbial communities associated with Rhizoctonia damage at the field and disease patch scale. Appl. Soil Ecol. 2014, 78, 37–47. [Google Scholar] [CrossRef]
- Cha, J.Y.; Han, S.; Hong, H.J.; Cho, H.; Kim, D.; Kwon, Y.; Kwon, S.K.; Crüsemann, M.; Bok Lee, Y.; Kim, J.F.; et al. Microbial and biochemical basis of a Fusarium wilt-suppressive soil. ISME J. 2016, 10, 119–129. [Google Scholar] [CrossRef]
- Zhang, J.; Zhang, N.; Liu, Y.X.; Zhang, X.; Hu, B.; Qin, Y.; Xu, H.; Wang, H.; Guo, X.; Qian, J.; et al. Root microbiota shift in rice correlates with resident time in the field and developmental stage. Sci. China Life Sci. 2018, 61, 613–621. [Google Scholar] [CrossRef]
- Ossowicki, A.; Tracanna, V.; Petrus, M.L.C.; van Wezel, G.; Raaijmakers, J.M.; Medema, M.H.; Garbeva, P. Microbial and volatile profiling of soils suppressive to Fusarium culmorum of wheat. Proc. Royal Soc. 2020, 287, 20192527. [Google Scholar] [CrossRef]
- Garbeva, P.; Postma, J.; van Veen, J.A.; van Elsas, J.D. Effect of above-ground plant species on soil microbial community structure and its impact on suppression of Rhizoctonia solani AG3. Environ. Microbiol. 2006, 8, 233–246. [Google Scholar] [CrossRef] [PubMed]
- Perez, C.; Dill-Macky, R.; Kinkel, L.L. Management of soil microbial communities to enhance populations of Fusarium graminearum-antagonists in soil. Plant Soil 2008, 302, 53–69. [Google Scholar] [CrossRef]
- Lisboa, B.B.; Bayer, C.; Passaglia, L.M.P.; de Oliveira Camargo, F.A.; Beneduzi, A.; Ambrosini, A.; Vargas, L.K. Soil fungistasis against Fusarium graminearum under different crop management systems. Rev. Bras. Cisnc. Solo 2015, 39, 69–77. [Google Scholar] [CrossRef]
- Zhao, Y.; Selvaraj, J.N.; Xing, F.; Zhou, L.; Wang, Y.; Song, H.; Tan, X.; Sun, L.; Sangare, L.; Folly, Y.M.E.; et al. Antagonistic Action of Bacillus subtilis Strain SG6 on Fusarium graminearum. PLoS ONE 2014, 9, e0092486. [Google Scholar] [CrossRef]
- Leplat, J.; Friberg, H.; Abid, M.; Christian, C. Survival of Fusarium graminearum, the causal agent of Fusarium head blight. A review. Agron. Sustain. Dev. 2012, 33, 97–111. [Google Scholar] [CrossRef]
- Leplat, J.; Heraud, C.; Gautheron, E.; Mangin, P.; Falchetto, L.; Steinberg, C. Colonization dynamic of various crop residues by Fusarium graminearum monitored through real-time PCR measurements. J. Appl. Microbiol. 2016, 121, 1394–1405. [Google Scholar] [CrossRef]
- Pereyra, S.A.; Dill-Macky, R.; Sims, A.L. Survival and inoculum production of Gibberella zeae in wheat residue. Plant Dis. 2004, 88, 724–730. [Google Scholar] [CrossRef]
- Jahanzad, E.; Barker, A.V.; Hashemi, M.; Eaton, T.; Sadeghpour, A.; Weis, S.A. Nitrogen release dynamics and decomposition of buried and surface cover crop residues. Agron. J. 2016, 108, 1735–1741. [Google Scholar] [CrossRef]
- Sievers, T.; Cook, R.L. Aboveground and root decomposition of cereal rye and hairy vetch cover crops. Soil Sci. Soc. Am. J. 2018, 82, 147–155. [Google Scholar] [CrossRef]
- Boer, W.; de Verheggen, P.; Paulien, J.A.; Gunnewiek, K.; Kowalchuk, G.A.; van Veen, J.A. Microbial community composition affects soil fungistasis. Appl. Environ. Microbiol. 2003, 69, 835–844. [Google Scholar] [CrossRef]
- Ghini, R.; Zaroni, M.M.H. Relação entre coberturas vegetais e supressividade de solos a Rhizoctonia solani. Fitopatol. Bras. 2001, 26, 10–15. [Google Scholar] [CrossRef]
- Garbeva, P.; Hol, W.H.G.; Termorshuizen, A.J.; Kowalchuk, G.A.; de Boer, W. Fungistasis and general soil biostasis—A new synthesis. Soil Biol. Biochem. 2011, 43, 469–477. [Google Scholar] [CrossRef]
- Bonanomi, G.; Capodilupo, M.; Incerti, G.; Gaglione, S.A.; Scala, F. Fungal diversity increases soil fungistasis and resistance to microbial invasion by a non resident species. Biol. Control 2014, 72, 38–45. [Google Scholar] [CrossRef]
- Gong, A.D.; Li, H.P.; Yuan, Q.S.; Song, X.S.; Yao, W.; He, W.J.; Zhang, J.B.; Liao, Y.C. Antagonistic mechanism of iturin A and plipastatin A from Bacillus amyloliquefaciens S76-3 from wheat spikes against Fusarium graminearum. PLoS ONE 2015, 10, e0116871. [Google Scholar] [CrossRef]
- Lee, T.; Park, D.; Kim, K.; Lim, S.M.; Yu, N.H.; Kim, S.; Kim, H.Y.; Jung, K.S.; Jang, J.Y.; Park, J.C.; et al. Characterization of Bacillus amyloliquefaciens DA12 showing potent antifungal activity against mycotoxigenic Fusarium species. Plant Pathol. J. 2017, 33, 499–507. [Google Scholar] [CrossRef]
- Xu, S.; Wang, Y.; Hu, J.; Chen, X.; Qiu, Y.; Shi, J.; Wang, G.; Xu, J. Isolation and characterization of Bacillus amyloliquefaciens MQ01, a bifunctional biocontrol bacterium with antagonistic activity against Fusarium graminearum and biodegradation capacity of zearalenone. Food Control 2021, 130, 108259. [Google Scholar] [CrossRef]
- Madriz-Ordeñana, K.; Pazarlar, S.; Jørgensen, H.J.L.; Nielsen, T.K.; Zhang, Y.; Nielsen, K.L.; Hansen, L.H.; Thordal-Christensen, H. The Bacillus cereus strain EC9 primes the plant immune system for superior biocontrol of Fusarium oxysporum. Plants 2022, 11, 687. [Google Scholar] [CrossRef] [PubMed]
- Agarwal, M.; Dheeman, S.; Dubey, R.C.; Kumar, P.; Maheshwari, D.K.; Bajpai, V.K. Differential antagonistic responses of Bacillus pumilus MSUA3 against Rhizoctonia solani and Fusarium oxysporum causing fungal diseases in Fagopyrum esculentum Moench. Microbiol. Res. 2017, 205, 40–47. [Google Scholar] [CrossRef]
- Ntushelo, K.; Ledwaba, L.K.; Rauwane, M.E.; Adebo, O.A.; Njobeh, P.B. The Mode of Action of Bacillus species against Fusarium graminearum, tools for investigation, and future prospects. Toxins 2019, 11, 606. [Google Scholar] [CrossRef]
- Cao, Y.; Xu, Z.; Ling, N.; Yuan, Y.; Yang, X.; Chen, L.; Shen, B.; Shen, Q. Isolation and identification of lipopeptides produced by B. subtilis SQR 9 for suppressing Fusarium wilt of cucumber. Sci. Hortic. 2012, 135, 32–39. [Google Scholar] [CrossRef]
- Alvarez, F.; Castro, M.; Príncipe, A.; Borioli, G.; Fischer, S.; Mori, G.; Jofré, E. The plant-associated Bacillus amyloliquefaciens strains MEP218 and ARP23 capable of producing the cyclic lipopeptides iturin or surfactin and fengycin are effective in biocontrol of sclerotinia stem rot disease. J. Appl. Microbiol. 2012, 112, 159–174. [Google Scholar] [CrossRef] [PubMed]
- Leslie, J.F.; Summerell, B.A. The Fusarium Laboratory Manual; Blackwell Professional: Ames, IA, USA, 2006; p. 388. [Google Scholar]
- Sneideris, D.; Ivanauskas, A.; Prakas, P.; Butkauskas, D.; Treikale, O.; Kadziene, G.; Rasiukeviciute, N.; Kelpsiene, J.; Suproniene, S. Population Structure of Fusarium graminearum isolated from different sources in one area over the course of three years. Phytopathology 2020, 110, 1312–1318. [Google Scholar] [CrossRef]
- Nicolaisen, M.; Supronienė, S.; Nielsen, L.K.; Lazzaro, I.; Spliid, N.H.; Justesen, A.F. Real-time PCR for quantification of eleven individual Fusarium species in cereals. J. Microbiol. Methods 2009, 76, 234–240. [Google Scholar] [CrossRef] [PubMed]
- Haubensaka, K.A.; Harta, S.C.; Starkb, J.M. Influences of chloroform exposure time and soil water content on C and N release in forest soils. Soil. Biol. Biochem. 2002, 34, 1549–1562. [Google Scholar] [CrossRef]
- Barghouthi, A.A. A universal method for the identification of bacteria based on general PCR primers. Indian J. Microbiol. 2011, 51, 430–444. [Google Scholar] [CrossRef]

| Treatment | Mean | F–Act. | Probability | |
|---|---|---|---|---|
| Year | 2016 | 14.9 | 2.3 | 0.1391 |
| 2017 | 25.0 | |||
| Sampling time | Renewal of vegetation | 27.5 * | 5.07 * | 0.0312 |
| After harvesting | 12.5 * | |||
| Tillage practice | Conventional tillage | 6.9 ** | 4.58 * | 0.0175 |
| Reduced tillage | 21.6 | |||
| No tillage | 31.5 * |
| Treatment | Mean, 2016 | Mean, 2017 | |
|---|---|---|---|
| Factor A | Conventional tillage | 80.6 | 82.3 * |
| Reduced tillage | 80.2 | 79.7 | |
| No-tillage | 79.5 | 79.4 | |
| F–act. Probability | 1.89 | 3.97 * | |
| 0.1726 | 0.0323 | ||
| Factor B | BBCH 29–33 | 78.6 | 78.0 ** |
| BBCH 69/77 | 81.7 | 82.5 ** | |
| After harvesting | 80.0 | 80.9 | |
| F–act. Probability | 0.24 | 7.92 ** | |
| 0.7886 | 0.0023 | ||
| F–act. A × B Probability A × B | 3.38 * | 2.27 | |
| 0.0250 | 0.0909 |
| No. | Isolate Code | Soil Sampling Details | Antagonistic Activity |
|---|---|---|---|
| 1. | 1–1 | Conventional tillage | + |
| 2. | 2–6 | Conventional tillage | + |
| 3. | 2–7 | Conventional tillage | + |
| 4. | 2–8 | Conventional tillage | + |
| 5. | 14–54 | Conventional tillage | ++ |
| 6. | 15–60 | Conventional tillage | ++ |
| 7. | 16–62 | Conventional tillage | ++ |
| 8. | 16–63 | Conventional tillage | + |
| 9. | 6–16 | Reduced tillage | ++ |
| 10. | 6–17 | Reduced tillage | + |
| 11. | 7–21 | Reduced tillage | ++ |
| 12. | 7–25 | Reduced tillage | ++ |
| 13. | 8–28 | Reduced tillage | ++ |
| 14. | 17–68 | Reduced tillage | ++ |
| 15. | 17–70 | Reduced tillage | ++ |
| 16. | 18–73 | Reduced tillage | + |
| 17. | 19–79 | Reduced tillage | ++ |
| 18. | 20–84 | Reduced tillage | ++ |
| 19. | 11–40 | No-tillage | ++ |
| 20. | 12–43 | No-tillage | ++ |
| 21. | 12–45 | No-tillage | +++ |
| 22. | 21–86 | No-tillage | ++ |
| 23. | 24–101 | No-tillage | ++ |
| Autumn Tillage Treatments | Year of Establishment | Abbreviation |
|---|---|---|
| Conventional tillage (ploughing 22–24 cm) | Since 1956 | CT |
| Reduced tillage (harrowing 8–10 cm) | Since 2003 | RT |
| No-tillage (direct drilling) | Since 2003 | NT |
| Month | Average Air Temperature (°C) | Amount of Rainfall (mm) | No. of Days with Rainfall ≥ 0.1 mm | Mean, 1924–2016 | ||||
|---|---|---|---|---|---|---|---|---|
| 2016 | 2017 | 2016 | 2017 | 2016 | 2017 | Air Temperature (°C) | Amount of Rainfall (mm) | |
| April | 7.1 | 5.6 | 59.5 | 48.2 | 16 | 18 | 5.9 | 37.4 |
| May | 15.0 | 12.8 | 27.3 | 3.4 | 5 | 4 | 12.3 | 51.5 |
| June | 17.5 | 15.4 | 57.4 | 72.1 | 10 | 17 | 15.7 | 62.0 |
| July | 18.6 | 16.7 | 128.2 (87.4) | 153.8 | 16 (13) | 15 | 17.7 | 76.7 |
| August | 17.1 | 17.3 | 109.2 | 53.2 (53.2) | 15 | 12 (12) | 16.8 | 73.6 |
| April–August | 15.1 | 13.6 | 381.6 (231.6) | 330.7 (330.7) | 62 (44) | 66 (66) | 13.7 | 301.2 |
Disclaimer/Publisher’s Note: The statements, opinions and data contained in all publications are solely those of the individual author(s) and contributor(s) and not of MDPI and/or the editor(s). MDPI and/or the editor(s) disclaim responsibility for any injury to people or property resulting from any ideas, methods, instructions or products referred to in the content. |
© 2023 by the authors. Licensee MDPI, Basel, Switzerland. This article is an open access article distributed under the terms and conditions of the Creative Commons Attribution (CC BY) license (https://creativecommons.org/licenses/by/4.0/).
Share and Cite
Supronienė, S.; Kadžienė, G.; Shamshitov, A.; Veršulienė, A.; Šneideris, D.; Ivanauskas, A.; Žvirdauskienė, R. Soil Fungistasis against Fusarium Graminearum under Different tillage Systems. Plants 2023, 12, 966. https://doi.org/10.3390/plants12040966
Supronienė S, Kadžienė G, Shamshitov A, Veršulienė A, Šneideris D, Ivanauskas A, Žvirdauskienė R. Soil Fungistasis against Fusarium Graminearum under Different tillage Systems. Plants. 2023; 12(4):966. https://doi.org/10.3390/plants12040966
Chicago/Turabian StyleSupronienė, Skaidrė, Gražina Kadžienė, Arman Shamshitov, Agnė Veršulienė, Donatas Šneideris, Algirdas Ivanauskas, and Renata Žvirdauskienė. 2023. "Soil Fungistasis against Fusarium Graminearum under Different tillage Systems" Plants 12, no. 4: 966. https://doi.org/10.3390/plants12040966
APA StyleSupronienė, S., Kadžienė, G., Shamshitov, A., Veršulienė, A., Šneideris, D., Ivanauskas, A., & Žvirdauskienė, R. (2023). Soil Fungistasis against Fusarium Graminearum under Different tillage Systems. Plants, 12(4), 966. https://doi.org/10.3390/plants12040966

